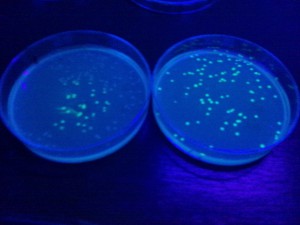

3年生「遺伝子検査学実験」遺伝子組換え実験
2011年8月12日「遺伝子検査学実験」担当、福島です。
実験は、6日間の日程ですが、後半、3日間は、遺伝子組換え実験です。
まず、遺伝子組換え用の大腸菌を培養し、コンピテントセルを作ります。
30分ごとに吸光度を測り、
大腸菌の増え具合を観察します。
大腸菌がとても元気に増えている時期に
塩化カルシウム溶液で処理すると、
外来DNAを取り込みやすくなった大腸菌(コンピテントセル)のできあがりです。
プラスミドベクターとオワンクラゲ由来の緑色蛍光タンパク質の遺伝子をつなげて、
大腸菌に形質転換します。
すると、
学生の撮った写真をもらいました。
ありがとう!!!
ブラックライトを当てると
クラゲのように緑蛍光に光る大腸菌のできあがります。
明日は、この大腸菌に入れたクラゲの遺伝子を回収し、
確認実験を行います!